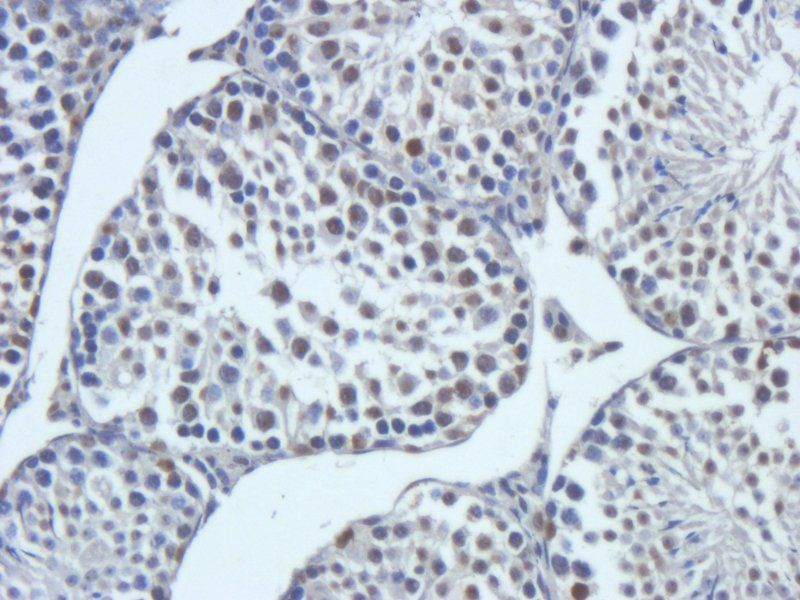
产品细节图片6

相关产品推荐更多 >
万千商家帮你免费找货
0 人在求购买到急需产品
- 详细信息
- 文献和实验
- 技术资料
- 抗体名:
C5a antibody抗体
- 抗体英文名:
C5a antibody
- 靶点:
C5a. The antibody detects endogenous levels of C5a
- 浓度:
- 100 μg (in 200 μl): 0.5 mg/ml- 200 μg (in 400 μl): 0.5 mg/ml
- 应用范围:
ELISA, IHC-P
- 宿主:
Rabbit
- 适应物种:
Human, Mouse, Rat
- 保质期:
6-12个月
- 抗原来源:
详询
- 目录编号:
orb308733
- 级别:
科研级
- 库存:
88
- 供应商:
biorbyt
- 标记物:
Unconjugated
- 克隆性:
Polyclonal
- 形态:
Liquid: 10 mM PBS, pH 7.4 with 10 mg/ml rAlbumin, 0.03% Proclin 300 and 25% glycerol
- 亚型:
IgG
- 免疫原:
KLH conjugated synthetic peptide derived from human C5a. Please contact us for the exact immunogen sequence. The peptide is available as orb374887.
- 规格:
100 ug
别名:anti anaphylatoxin C5a analog antibody, anti Anaphylatoxin C5a antibody, anti C5a anaphylatoxin antibody, anti C5a des Arg antibody, anti Complement C5 alpha chain antibody, anti Complement C5 antibody, anti Complement component C5 antibody, anti Complement component C5a antibody, anti CPAMD4 antibody
免疫原:KLH conjugated synthetic peptide derived from human C5a. Please contact us for the exact 免疫原 sequence. The peptide is available as orb374887.
分子量:9 kDa
应用稀释比例:IHC-P: 1:200
纯度:Polyclonal antibodies are purified by peptide affinity chromatography
保存说明:Maintain refrigerated at 2-8°C for up to 2 weeks. For long term storage store at -20°C in small aliquots to prevent freeze-thaw cycles.
NCBI:001735, 001726
Entrez:727
UniProt ID:P06684, P08650, P01031
Note:For research use only.

风险提示:丁香通仅作为第三方平台,为商家信息发布提供平台空间。用户咨询产品时请注意保护个人信息及财产安全,合理判断,谨慎选购商品,商家和用户对交易行为负责。对于医疗器械类产品,请先查证核实企业经营资质和医疗器械产品注册证情况。
 文献和实验
文献和实验上海西唐生物科技有限公司 021-55229872, 65333639 www.westang.com 小鼠补体C5a (C5a)ELISA 试剂盒 ( 用于血清、血浆、细胞培养上清液和生物体液内 ) 原理 本实验采用双抗体夹心 ABC-ELISA 法。用抗小鼠 C5a 单抗包被于酶标板上,标准品和样品中的 C5a与单抗结合,加入生物素化的抗小鼠 C5a ,形成
人补体片段C5a (C5a)ELISA 试剂盒 ( 用于血清、血浆、细胞培养上清液和其它生物体液内 ) 原理 本实验采用双抗体夹心 ABC-ELISA 法。用抗人 C5a 单抗包被于酶标板上,标准品和样品中的 C5a与单抗结合,加入生物素化的抗人 C5a ,形成免疫复合物连接在板上,辣根过氧化物酶标记的 Streptavidin 与生物素结合,加入底物工作液显蓝色,最后加终止液硫酸,在 450
一、实验原理 将抗C5a单克隆抗体包被固相聚苯乙烯板,加入经聚乙二醇(PEG)处理的待测样本,然后依次加入兔抗人C5a-IgC多克隆抗体和过氧化物酶标记的猪抗兔IsC,再加入底物2,2’-连氮-双(3-乙基苯骈唑啉-6-磺酸盐)(ABTS)和H2O2显色,于酶标仪405 mn处测定每分钟光密度增加量(OD/min),以OD/min为纵坐标,C5a标准晶浓度为横坐标绘制标准曲线图,求出待测样本中C5a的含量。 二、实验试剂 1. PBSPH7.2
 技术资料
技术资料暂无技术资料 索取技术资料











